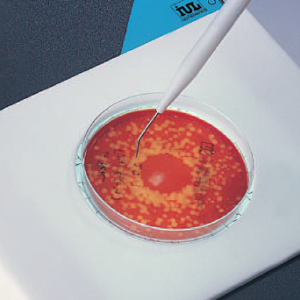
Stainless Contact Pointer

II. Agar preparation and pouring
III. Spiral plating
IV. Automated colony counting